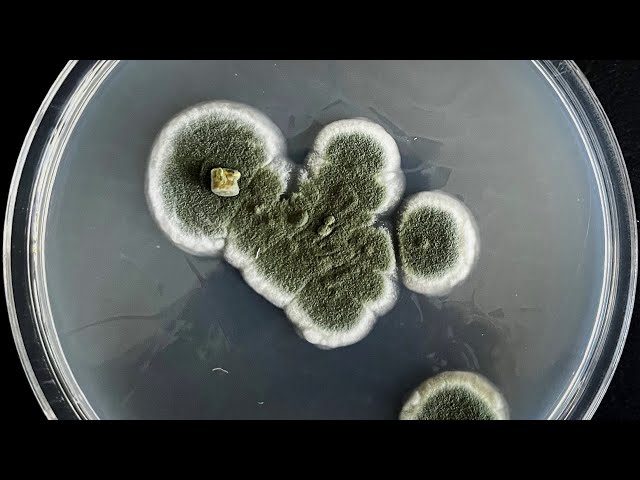
Uruchom film

Akademia Zrównoważonego Rozwoju
Zrównoważony rozwój – czyli jaki właściwie? Hasło to pozornie tylko brzmi górnolotnie, a to przecież kwestia, która dotyczy nas wszystkich. Jak mądrze gospodarować zasobami – naturalnymi, przyrodniczymi, jak kształtować relacje społeczne, polityczne i gospodarcze, by żyło nam się wszystkim dobrze, bezpiecznie i zdrowo? Jak mierzyć się ze współczesnymi wyzwaniami, z których zmiany klimatyczne i związane z nimi zjawiska wydają się najistotniejsze? I co szczególnie ważne w tej koncepcji – jak nie zaprzepaścić szans kolejnych pokoleń na dobre życie?
Dlatego w 2015 ONZ ustanowiła 17 Celów Zrównoważonego Rozwoju – jako Globalną Agendę 2030 – pewne ramy, które wytyczają kierunki działań dla rządów i społeczeństw.

Pracownicy UAM w swoich badaniach i aktywnościach w te właśnie cele się wpisują – posłuchajcie sami, w jaki sposób.
Zapraszamy serdecznie w podróż po bardzo ciekawych, pełnych pasji opowieściach naszych naukowców i naukowczyń z różnych dziedzin – od lodowców, przez niesporczaki i torfowiska, po ekologię w fantastyce, refleksje o wzorcach konsumpcji, opowieści o życiu na lądzie i wodzie, ale także o przemyśle samochodowym i wiele innych!
W Akademii Zrównoważonego Rozwoju każdy znajdzie coś dla siebie!
Osoby zainteresowane wystąpieniem w ramach serii proszone są o kontakt z koordynatorką projektu:
Anna Schmidt-Fiedler
E-mail: afiedler@amu.edu.pl
Tel.: 61 829 47 55